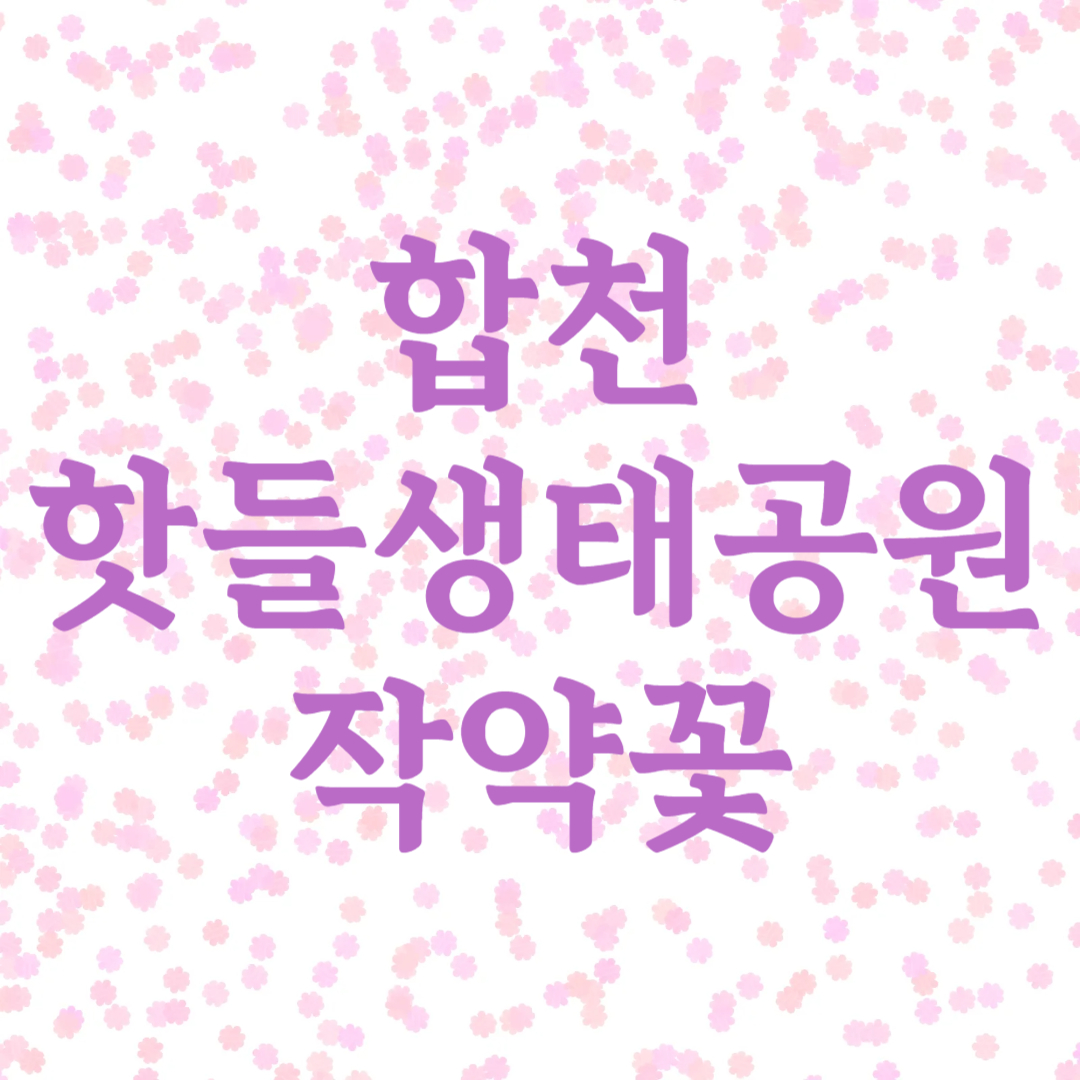
합천 핫들생태공원 작약꽃

합천 핫들생태공원 작약꽃 구경 정보
경상남도 합천군 율곡면 임북리에 위치한 합천 핫들생태공원은 봄이 되면 전국에서 많은 사람들이 찾는 작약꽃 명소입니다. 매년 5월이면 핫들생태공원은 분홍, 붉은색, 흰색 등 다채로운 색상의 작약꽃이 만개하여, 마치 꽃의 융단을 펼쳐놓은 듯한 장관을 연출합니다. 이번 글에서는 합천 핫들생태공원의 작약꽃 개화 시기, 볼거리, 편의시설, 방문 팁 등 작약꽃구경에 필요한 모든 정보를 자세히 안내해 드리겠습니다.
합천 핫들생태공원 작약꽃 개화시기
합천 핫들생태공원의 작약꽃은 5월 초부터 개화하기 시작해, 5월 중순경에 절정을 이룹니다. 해마다 기후에 따라 개화 시기가 조금씩 달라질 수 있지만, 보통 5월 10일 전후가 만개 시기입니다. 작약꽃은 약 2주 동안 아름다운 자태를 뽐내므로, 이 시기에 방문하면 가장 화려한 꽃밭을 만날 수 있습니다. 겹꽃과 홑꽃이 어우러져 다양한 형태와 색상으로 방문객의 눈길을 사로잡습니다.


작약꽃의 매력과 꽃말
작약꽃은 크고 풍성한 꽃잎과 우아한 자태로 예로부터 많은 사랑을 받아온 꽃입니다. 특히, 분홍색과 붉은색, 흰색 등 다양한 색상이 어우러져 화려하면서도 고급스러운 분위기를 자아냅니다. 작약꽃의 꽃말은 ‘수줍음’으로, 수줍게 피어나는 모습이 방문객의 마음까지 설레게 합니다.



핫들생태공원 위치 및 주차정보
- 주소: 경남 합천군 율곡면 임북리(합천읍 합천리 1628번지 하수종말처리장 앞)
- 주차: 공원 내 주차장이 넉넉하게 마련되어 있으나, 주말에는 다소 혼잡할 수 있습니다. 대형차량은 신소양체육공원 주차장(영창리 898번지) 이용 후 도보 이동을 권장합니다.
- 진입도로: 일부 구간 도로 공사로 인해 우회도로를 이용해야 할 수 있으니, 방문 전 합천군청 홈페이지나 네비게이션 안내를 참고하세요.
- 입장료: 무료
- 운영시간: 상시 개방(야간에는 안전상 출입 제한 가능)



합천 핫들생태공원, 무엇이 특별할까?
1. 넓고 아름다운 꽃밭
핫들생태공원은 약 6천 평(2ha) 규모의 넓은 평지에 수만 송이의 작약꽃이 심어져 있습니다. 꽃밭 사이로 산책로가 잘 조성되어 있어, 꽃을 가까이에서 감상하며 산책을 즐길 수 있습니다. 특히, 황강과 합천천이 만나는 지점에 위치해 있어, 강가 풍경과 어우러진 꽃밭이 더욱 아름답습니다.
2. 다양한 체험과 이벤트
작약꽃 개화 시기에는 플리마켓, 푸드트럭, 작약꽃 체험 프로그램, 작약 모종 판매 등 다양한 이벤트가 열려 가족, 연인, 친구와 함께 즐거운 시간을 보낼 수 있습니다. 아이들과 함께하는 체험 프로그램도 마련되어 있어, 가족 단위 방문객에게도 인기가 높습니다.
3. 편리한 편의시설
공원 내에는 포토존, 벤치, 쉼터, 화장실, 넓은 주차장 등 방문객을 위한 편의시설이 잘 갖추어져 있습니다. 특히, 작약꽃밭 곳곳에 포토존이 마련되어 있어 인생샷을 남기기에 좋습니다.
4. 사진 찍기 좋은 명소
작약꽃밭은 사진작가와 인플루언서들에게도 인기 있는 촬영지입니다. 이른 아침이나 해질 무렵 방문하면, 은은한 햇살과 함께 더욱 아름다운 사진을 남길 수 있습니다.



작약꽃구경 100% 즐기는 팁
- 평일 오전 방문 추천
주말에는 방문객이 많아 혼잡할 수 있으니, 한적하게 꽃구경을 원한다면 평일 오전 방문을 추천합니다. - 편안한 복장과 신발
꽃밭 산책로가 넓으니, 편안한 복장과 운동화를 착용하세요. - 카메라와 보조배터리 준비
포토존이 많아 사진 촬영이 필수! 카메라와 스마트폰, 보조배터리를 챙기면 좋습니다. - 날씨 확인
야외 행사이므로, 비가 오는 날은 꽃구경이 어려울 수 있으니 방문 전 날씨를 꼭 확인하세요.



합천 핫들생태공원 작약꽃구경, 이런 분께 추천해요
- 봄꽃 명소를 찾는 여행자
- 가족 나들이, 연인 데이트, 친구들과의 봄 소풍
- 인생샷을 남기고 싶은 분
- 자연과 함께 힐링하고 싶은 분
올봄, 합천 핫들생태공원에서 펼쳐지는 작약꽃의 향연 속으로 떠나보세요. 화려한 꽃밭과 함께 소중한 추억을 남길 수 있는 최고의 봄꽃 명소, 합천 핫들생태공원에서 특별한 하루를 보내시길 바랍니다!





